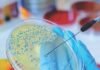
The Critical Importance of Testing for Mycotoxins in Animal Feed

Reimagining Rural India: CEAH’s Vision for Animal Husbandry in Viksit Bharat
In an exclusive interaction, Dr Mahesh PS, Joint Commissioner and Director of CEAH, shares insights on the future of India's livestock sector.
At Hesaraghatta, the...
Reimagining Rural India: CEAH’s Vision for Animal Husbandry in Viksit Bharat
In an exclusive interaction, Dr Mahesh PS, Joint Commissioner and Director of CEAH, shares insights on the future of India's livestock sector.
At Hesaraghatta, the...
From Gaps to Growth: The Case for a National Feed Security Roadmap
On the occasion of National Farm Animals Day, it is important to reflect on the indispensable role livestock plays in shaping India's agricultural and...
From Assumed Nutrition to Measured Precision: The Enzyme Revolution
In an era where feed efficiency, sustainability, and precision nutrition are redefining animal agriculture, enzymes have emerged as a critical tool in modern feed formulation....
Key Takeaways from Gut Health Forum 2026: Gut to Immunity in...
The Gut Health Forum 2026, organized by Nanovet Nutrition Pvt. Ltd. in collaboration with Andres Pintaluba S.A. (APSA), Spain, on 16 March in Hyderabad,...
Misinformation About Hormone Use in the Poultry Industry: Scientific Facts vs...
Introduction: Origin and Persistence of the Hormone Myth
One of the most widespread misconceptions surrounding poultry meat and eggs is the belief that growth hormones...
Process Optimization – Controlling non-value-added factors up to mixing
Think Grain Think Feed organized first session of Process Optimization webinar on 28th May with Mr M. Kanagaraj – a renowned Feed Milling expert...
Principles of mash conditioning
Conditioning is common to modify the physical properties of mash before it is delivered to the pellet die chamber. Most commonly, conditioning involves the...
Cooling- A critical process for pellet durability index & feed hygiene
The main objective of Cooling processin the pellet formationis to withdraw heat and moisture from dense mass to forms shaped mass. Theoretically, the amount...